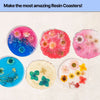
DIY Resin Coaster Kit

Create stunning coasters with our DIY Resin Coaster Kit, designed to help you craft a set of 5 beautiful coasters. This beginner-friendly kit includes all the materials and instructions you need to get started.
What is Epoxy Resin?
Epoxy resin is a liquid chemical that hardens into a solid state when mixed with a hardening agent. It is not for consumption, and direct skin contact should be avoided. The kit uses a non-industrial resin, ensuring safety when used according to the provided instructions. Explore the endless creative possibilities with this versatile material.
Highlights:
1. Detailed Instructions: Access a comprehensive step-by-step video workshop covering resin basics, mixing, pouring, curing, and design tips.
2. Reusable Moulds: The silicone moulds are reusable, allowing you to create multiple coasters with additional resin refills.
3. Personalization: Preserve special memories or add unique designs to your coasters.
4. Beginner-Friendly: Suitable for ages 13 and up, with easy-to-follow instructions for creating your own coasters at home
REVIEW
FAQs
Q. When will my order get dispatched?
It usually takes upto 3 working days to dispatch the order from the warehouse.However, incase of personalised products it may take upto 7 working days to dispatch the order from the warehouse.
Q. How can I track my order?
Upon dispatch, an email will be sent out with tracking details which will enable you to track your order.You will also be sent an sms with tracking details.
Q. What are the shipping timelines?
The time taken to deliver the products to you depends on the location and pincode of delivery.Usually, metro cities will receive the products within 5-7 days of shipping the product and non-metros will receive the product in 7-10 days of shipping.
Q. Do I have to pay for the shipping?
As a promotional offer we provide free shipping to all our valuable customers which is subject to change as and when the promotional offer expires.
Q. Can i return a product?
The time taken to deliver the products to you depends on the location and pincode of delivery.Usually, metro cities will receive the products within 5-7 days of shipping the product and non-metros will receive the product in 7-10 days of shipping.
Q. How can I initiate a return?
If the product is eligible for return, write to us at support@mumma.com within 48 hours of the receipt of the product along with photos and reason of return and we will have the process initiated upon scrutiny.
Q. Is it safe to pay on Mumma?
It is absolutely safe to pay on our portal as we use the latest encryption technology to store and safely transmit your personal and credit card information through our systems.All orders are processed through a secure checkout system.
Q. How will I know you received my order after payment deduction?
After you place an order with us we will share with you an order confirmation email with an order number to assure that an order has been successfully placed with us.